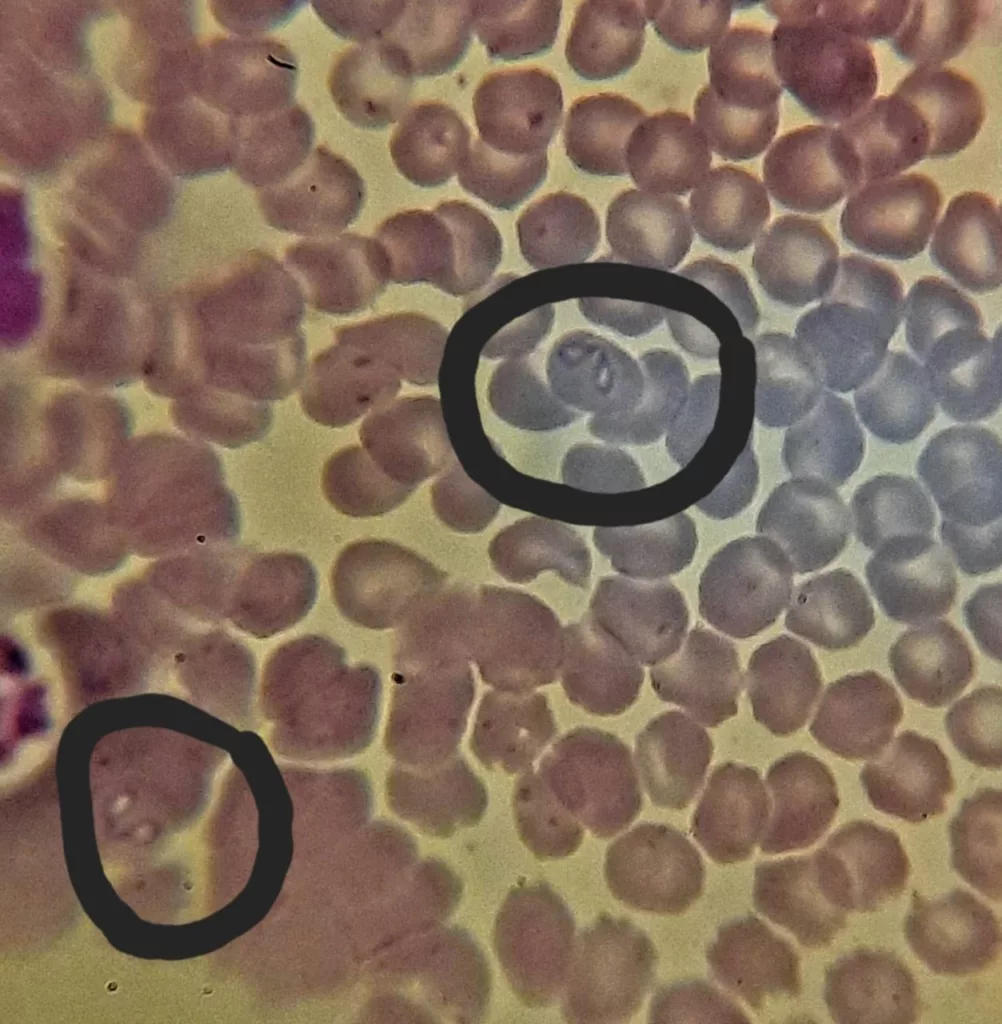

«Пироплазмоз приводит к гибели за две недели, микоплазмоз – «тихо убивает» за 7 лет, — рассказал ветеринар Василий Крыжанстовский.
–Как правило, приводят питомцев уже с запущенной формой болезни. Спасти удается не всегда».
Пироплазмоз — инвазионное заболевание собак передающееся с укусом клеща. Возбудителем является как правило два вида кровепаразитов (Babesia canis и Babesia gibsoni), инкубационный период в радиусе 3-7 дней. Заболевание характеризуется потерей аппетита, повышением температуры тела, угнетением активности, потемнением мочи, одышкой, на поздней стадии (14-й день) происходит разрушение крови и смерть.
По словам ветеринара, прививок не существует, способ защитить собаку или кошку — обработка от клеща, регулярная, даже зимой. Потому что в Туапсе зимы теплые и клещ кусает даже в январе. При обнаружении хотя бы одного из симптомов срочно обратиться к ветеринарному врачу. В мазке крови пироплазмы выглядят как «грустные глаза».
Если животное хорошо себя чувствует, не факт что оно ни чем не болеет. Родственник пироплазмы — инвазионное заболевание микоплазмоз (возбудитель (Mycoplasma canis) может 7 лет не давать о себе знать.
«Я называю эту болезнь «тихий убийца», потому что инкубация длится до 7 лет, и никак себя не проявляет, — говорит ветеринар. — А на последней стадии проявляется как быстрый пироплазмоз с той же симптоматикой.
Поэтому необходима периодическая диспансеризация. Каждая третья собака и каждая вторая кошка, имеющая доступ на улицу, заражена, вы просто об этом не знаете».




